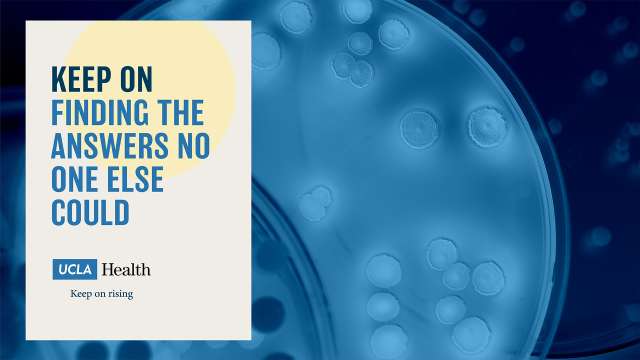

Brand Identity
Zoom Backgrounds
Select, then download the high resolution Zoom background to your computer. To apply the background screen, launch the Zoom app, then go to the Settings panel. Select Virtual Backgrounds from the list on the left. Then click the plus sign, select add image and upload to Zoom.